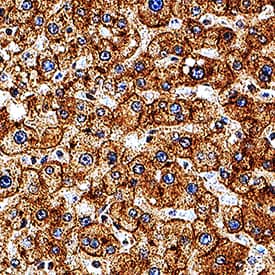
ASGR1/ASGPR1 antibody in Human Liver by Immunohistochemistry (IHC-P).

Human ASGR1/ASGPR1 Antibody
R&D Systems, part of Bio-Techne | Catalog # MAB43941


Key Product Details
Species Reactivity
Applications
Label
Antibody Source
Product Specifications
Immunogen
Gln62-Leu291
Accession # P07306
Specificity
Clonality
Host
Isotype
Scientific Data Images for Human ASGR1/ASGPR1 Antibody
Detection of ASGR1/ASGPR1 in HepG2 Human Cell Line by Flow Cytometry.
HepG2 human hepatocellular carcinoma cell line was stained with Mouse Anti-Human ASGR1/ASGPR1 Monoclonal Antibody (Catalog # MAB43941, filled histogram) or isotype control antibody (Catalog # MAB0041, open histogram), followed by PE-conjugated Anti-Mouse IgG Secondary Antibody (Catalog # F0102B). View our protocol for Staining Membrane-associated Proteins.ASGR1/ASGPR1 in Human Liver.
ASGR1/ASGPR1 was detected in immersion fixed paraffin-embedded sections of human liver using Mouse Anti-Human ASGR1/ASGPR1 Monoclonal Antibody (Catalog # MAB43941) at 15 µg/mL for 1 hour at room temperature followed by incubation with the Anti-Mouse IgG VisUCyte™ HRP Polymer Antibody (Catalog # VC001). Tissue was stained using DAB (brown) and counterstained with hematoxylin (blue). Specific staining was localized to cytoplasm and membranes in hepatocytes. View our protocol for IHC Staining with VisUCyte HRP Polymer Detection Reagents.Applications for Human ASGR1/ASGPR1 Antibody
CyTOF-ready
Flow Cytometry
Sample: HepG2 Human Cell Line
Immunohistochemistry
Sample: Immersion fixed paraffin-embedded sections of human liver
Formulation, Preparation, and Storage
Purification
Reconstitution
Formulation
Shipping
Stability & Storage
- 12 months from date of receipt, -20 to -70 °C as supplied.
- 1 month, 2 to 8 °C under sterile conditions after reconstitution.
- 6 months, -20 to -70 °C under sterile conditions after reconstitution.
Background: ASGR1/ASGPR1
The human asialoglycoprotein receptor (ASGPR) is an endocytic recycling receptor that belongs to the long-form subfamily of the C-type/Ca+2-dependent lectin family (1, 2, 3). It is a complex of two noncovalently-linked subunits, a major 46 kDa glycoprotein (ASGR1) and a minor 50 kDa glycoprotein (ASGR2). The major human ASGPR subunit, ASGR1 (also H1), is synthesized as a 291 amino acid (aa) type II transmembrane (TM) glycoprotein. It contains a 40 aa cytoplasmic region, a 21 aa TM segment, and a 230 aa extracellular domain (ECD) (4 - 6). The cytoplasmic region contains one palmitoylation site at Cys36 that is essential for ligand endocytosis and dissociation (7). The ECD contains two important structural regions. The first is a stalk region of 62 aa (aa 61 - 123) that contributes to noncovalent oligomerization. The second is a 118 aa, carbohydrate-binding, Ca+2-dependent C-type lectin domain (aa 161 - 278) that is stabilized by three Ca+2 ions (3, 8). Human ASGR1 ECD is 79% aa identical to mouse ASGR1 ECD. There are two minor (ASGR2) subunits that interact with ASGR1/H1 in a mutually exclusive manner to generate a functional ASGPR (9). They represent alternate splice forms of a type II TM protein. Termed H2b and H2c, H2b differs from H2c only by the presence of a 19 aa insert in its cytoplasmic region. This insert is significant because it allows serine phosphorylation of the cytoplasmic tail and provides for the majority of ASGPR ligand internalization (9). The stoichiometry of a functional ASGPR is unclear, but is suggested to be either a 2:2, 3:1 or 3:2 ratio of ASGR1/H1:ASGR2/H2 (9, 10, 11). ASGPR is found on hepatocytes and a subset of T cells (6, 12). ASGPR is reported to bind Gal (nonreducing), GalNAc, and sialic acid alpha2,6Gal and GalNAc (3, 13, 14, 15). This is generally within the context of triantennary or tetraantennary configurations (2). The sialic acid terminations are of particular interest because molecules with these motifs most likely represent the endogenous ligands for ASGPR (14).
References
- Stockert, R. J. (1995) Physiol. Rev. 75:591.
- Weigel, P.H. and J.H.N. Yik (2002) Biochim. Biophys. Acta 1572:341.
- Meier, M. et al. (2000) J. Mol. Biol. 300:857.
- Spiess, M. et al. (1985) J. Biol. Chem. 260:1979.
- Spiess, M. and H.F. Lodish (1986) Cell 44:177.
- Bischoff, J. et al. (1988) J. Cell Biol. 106:1067.
- Yik, J.H.N. et al. (2002) J. Biol. Chem. 277:40844.
- Monroe, R.S. and B.E. Huber (1994) Gene 148:237.
- Yik, J.H.N. et al. (2002) J. Biol. Chem. 277:23076.
- Bider, M.D. et al. (1996) J. Biol. Chem. 271:31996.
- Lodish, H. (1991) Trends Biochem. Sci. 16:374.
- Park, J-H. et al. (2006) Biotechnol. Lett. 28:1061.
- Westerlind, U. et al. (2004) Glyconj. J. 21:227.
- Park, E.I. et al. (2005) Proc. Natl. Acad. Sci. USA 102:17125.
- Park, E.I. et al. (2003) J. Biol. Chem. 278:4597.
Long Name
Alternate Names
Gene Symbol
UniProt
Additional ASGR1/ASGPR1 Products
Product Documents for Human ASGR1/ASGPR1 Antibody
Product Specific Notices for Human ASGR1/ASGPR1 Antibody
For research use only